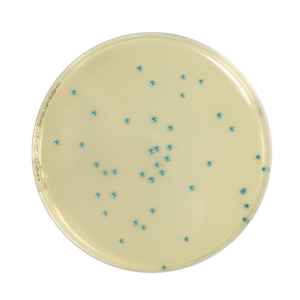

Validazione dei metodi rapidi dedicati alla microbiologia e verifica delle prestazioni sono due attività distinte e non sempre richieste.
In questo webinar verranno presentati esempi applicativi, per affrontare il compito nel modo più semplice possibile, senza spreco di tempo e di risorse.
A chi è rivolto:
Controllo qualità delle imprese alimentari e laboratori accreditati per l’analisi degli alimenti.
Relatore:
Dr Tarditi Massimo.
LA PARTECIPAZIONE E’ GRATUITA.



